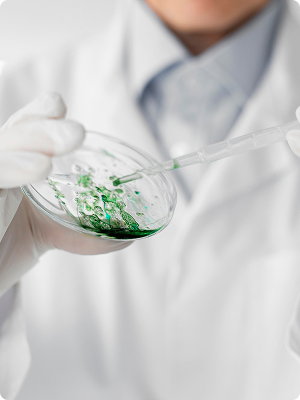
Laboratory

Fundada a través de la visión convergente de la Fundación Ciencia & Vida y Venturance Alternative Assets, combinamos capital, profundidad científica y experiencia operativa para ayudar a los fundadores a convertir la ciencia innovadora en negocios escalables.